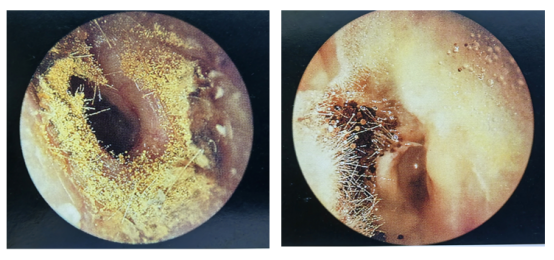

耳朵里长“脚气”?关注真菌性外耳道炎
点击数:loading... 发布时间:2025-10-20 文章作者:耳鼻喉科
多日阴雨连绵,不少人开始觉得耳朵发痒、潮湿,忍不住用棉签掏耳朵,可越掏越不舒服,甚至听力都受影响。去医院检查后,才知道自己得了真菌性外耳道炎。那么,你是否也有过类似的耳道不适?不妨对照看看,这些症状你中招了吗?

①耳道瘙痒难忍,忍不住想掏。
②耳内有潮湿感,甚至流出白色、黄色或黑色分泌物。
③听力轻微下降,感觉耳朵像被“堵住”。
④严重时伴随耳痛、耳鸣,按压耳屏或牵拉耳廓时疼痛加重。
如果你的耳道出现以上多种症状,别不当回事,这很可能是真菌性外耳道炎在“作祟”。
什么是真菌性外耳道炎?

真菌性外耳道炎是由外耳道内真菌感染引起的炎症,常见的致病菌有曲霉菌、念珠菌等。真菌性外耳道炎在温暖潮湿的环境下更容易发作,比如夏季出汗多、经常游泳或洗澡后耳道进水时,真菌就容易在耳道内滋生繁殖,引发耳痒、听力下降等不适。
与常见的细菌性耳道炎不同,真菌性外耳道炎的主要症状不是剧烈的疼痛,而是难以忍受的瘙痒。
什么是真菌性外耳道炎?
想要治好真菌性外耳道炎,首先得知道它为什么会找上门。真菌性外耳道炎的常见诱因包括:
1. 外耳道环境改变:经常游泳、耳道进水、外耳道不合理用药以及化脓性中耳炎反复发作或破坏耳道微生态环境,都可能促进真菌的生长繁殖。
2. 不当掏耳:频繁用棉签、发夹、挖耳勺等工具掏耳朵,不仅会损伤耳道皮肤屏障,还可能将外界真菌带入耳道,或把耳道内的分泌物推向深处,加重感染。
3. 长期使用抗生素滴耳液:部分人因耳道不适长期滥用抗生素滴耳液,会破坏耳道内正常的菌群平衡,导致真菌过度生长。
4. 免疫力低下:患有糖尿病、免疫系统疾病的人群,身体抵抗力较弱,也更容易受到真菌侵袭。
易复发?如何应对真菌性外耳道炎?

针对这一问题,医院耳鼻喉科特别开展了特色综合治疗方案,效果显著。具体治疗方案如下:
耳道清理:使用专业工具轻柔地清除耳道内的真菌痂皮和分泌物,确保药物能够直接接触病灶,从而提高治疗效果。
局部用药:根据患者的具体感染情况,选用合适的抗真菌滴耳液或涂抹抗真菌药膏。如果耳道出现肿胀严重、疼痛明显的情况,医生可能会短期使用糖皮质激素来减轻炎症。此外,若病情合并细菌感染,还需联合使用抗生素进行治疗。
物理治疗:采用红光治疗、半导体激光、微波治疗等物理疗法。这些疗法能够有效改善局部血液循环,抑制真菌的生长,从而缩短病程,加速患者的康复。
在日常生活中,患者也应注意保护耳朵。保持外耳道的干燥和清洁,尽量避免耳道进水。同时,要戒除挖耳、掏耳的习惯,以免损伤耳道皮肤,引发感染。在使用耳内抗生素时,应严格遵循医嘱,规范使用,切勿滥用滴耳液。
门诊地点:门诊楼4楼-耳鼻喉科门诊
预约咨询电话:0546—8175576